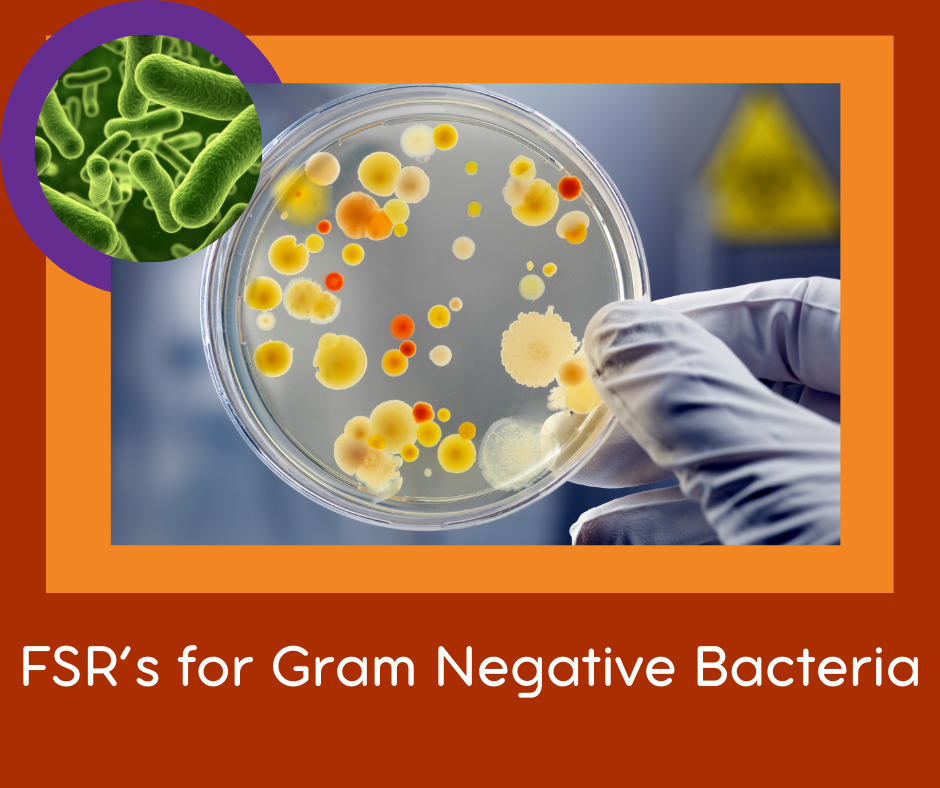

FSR set BN: Gram Negative Bacterial Infections:- 5x FSR's
FSR's are sound files that, when played on your body, influence the vibration of your body. The result of this is that your system can have a positive change in response to the sound.
This is the Resonance Treatment Gram Negative Bacteria. They plague many organs and often are resistant to antibiotics.
It may be a good idea to play these together with the general bacterial infection FSR's. The mix can often not be separated out.
List of FSRs:
- Gram Negative Bacteria
- Klebsiella Infections
- B Lactis Aerogenes
- Kingella Kingae 1
- Kinglella Kingae 2

